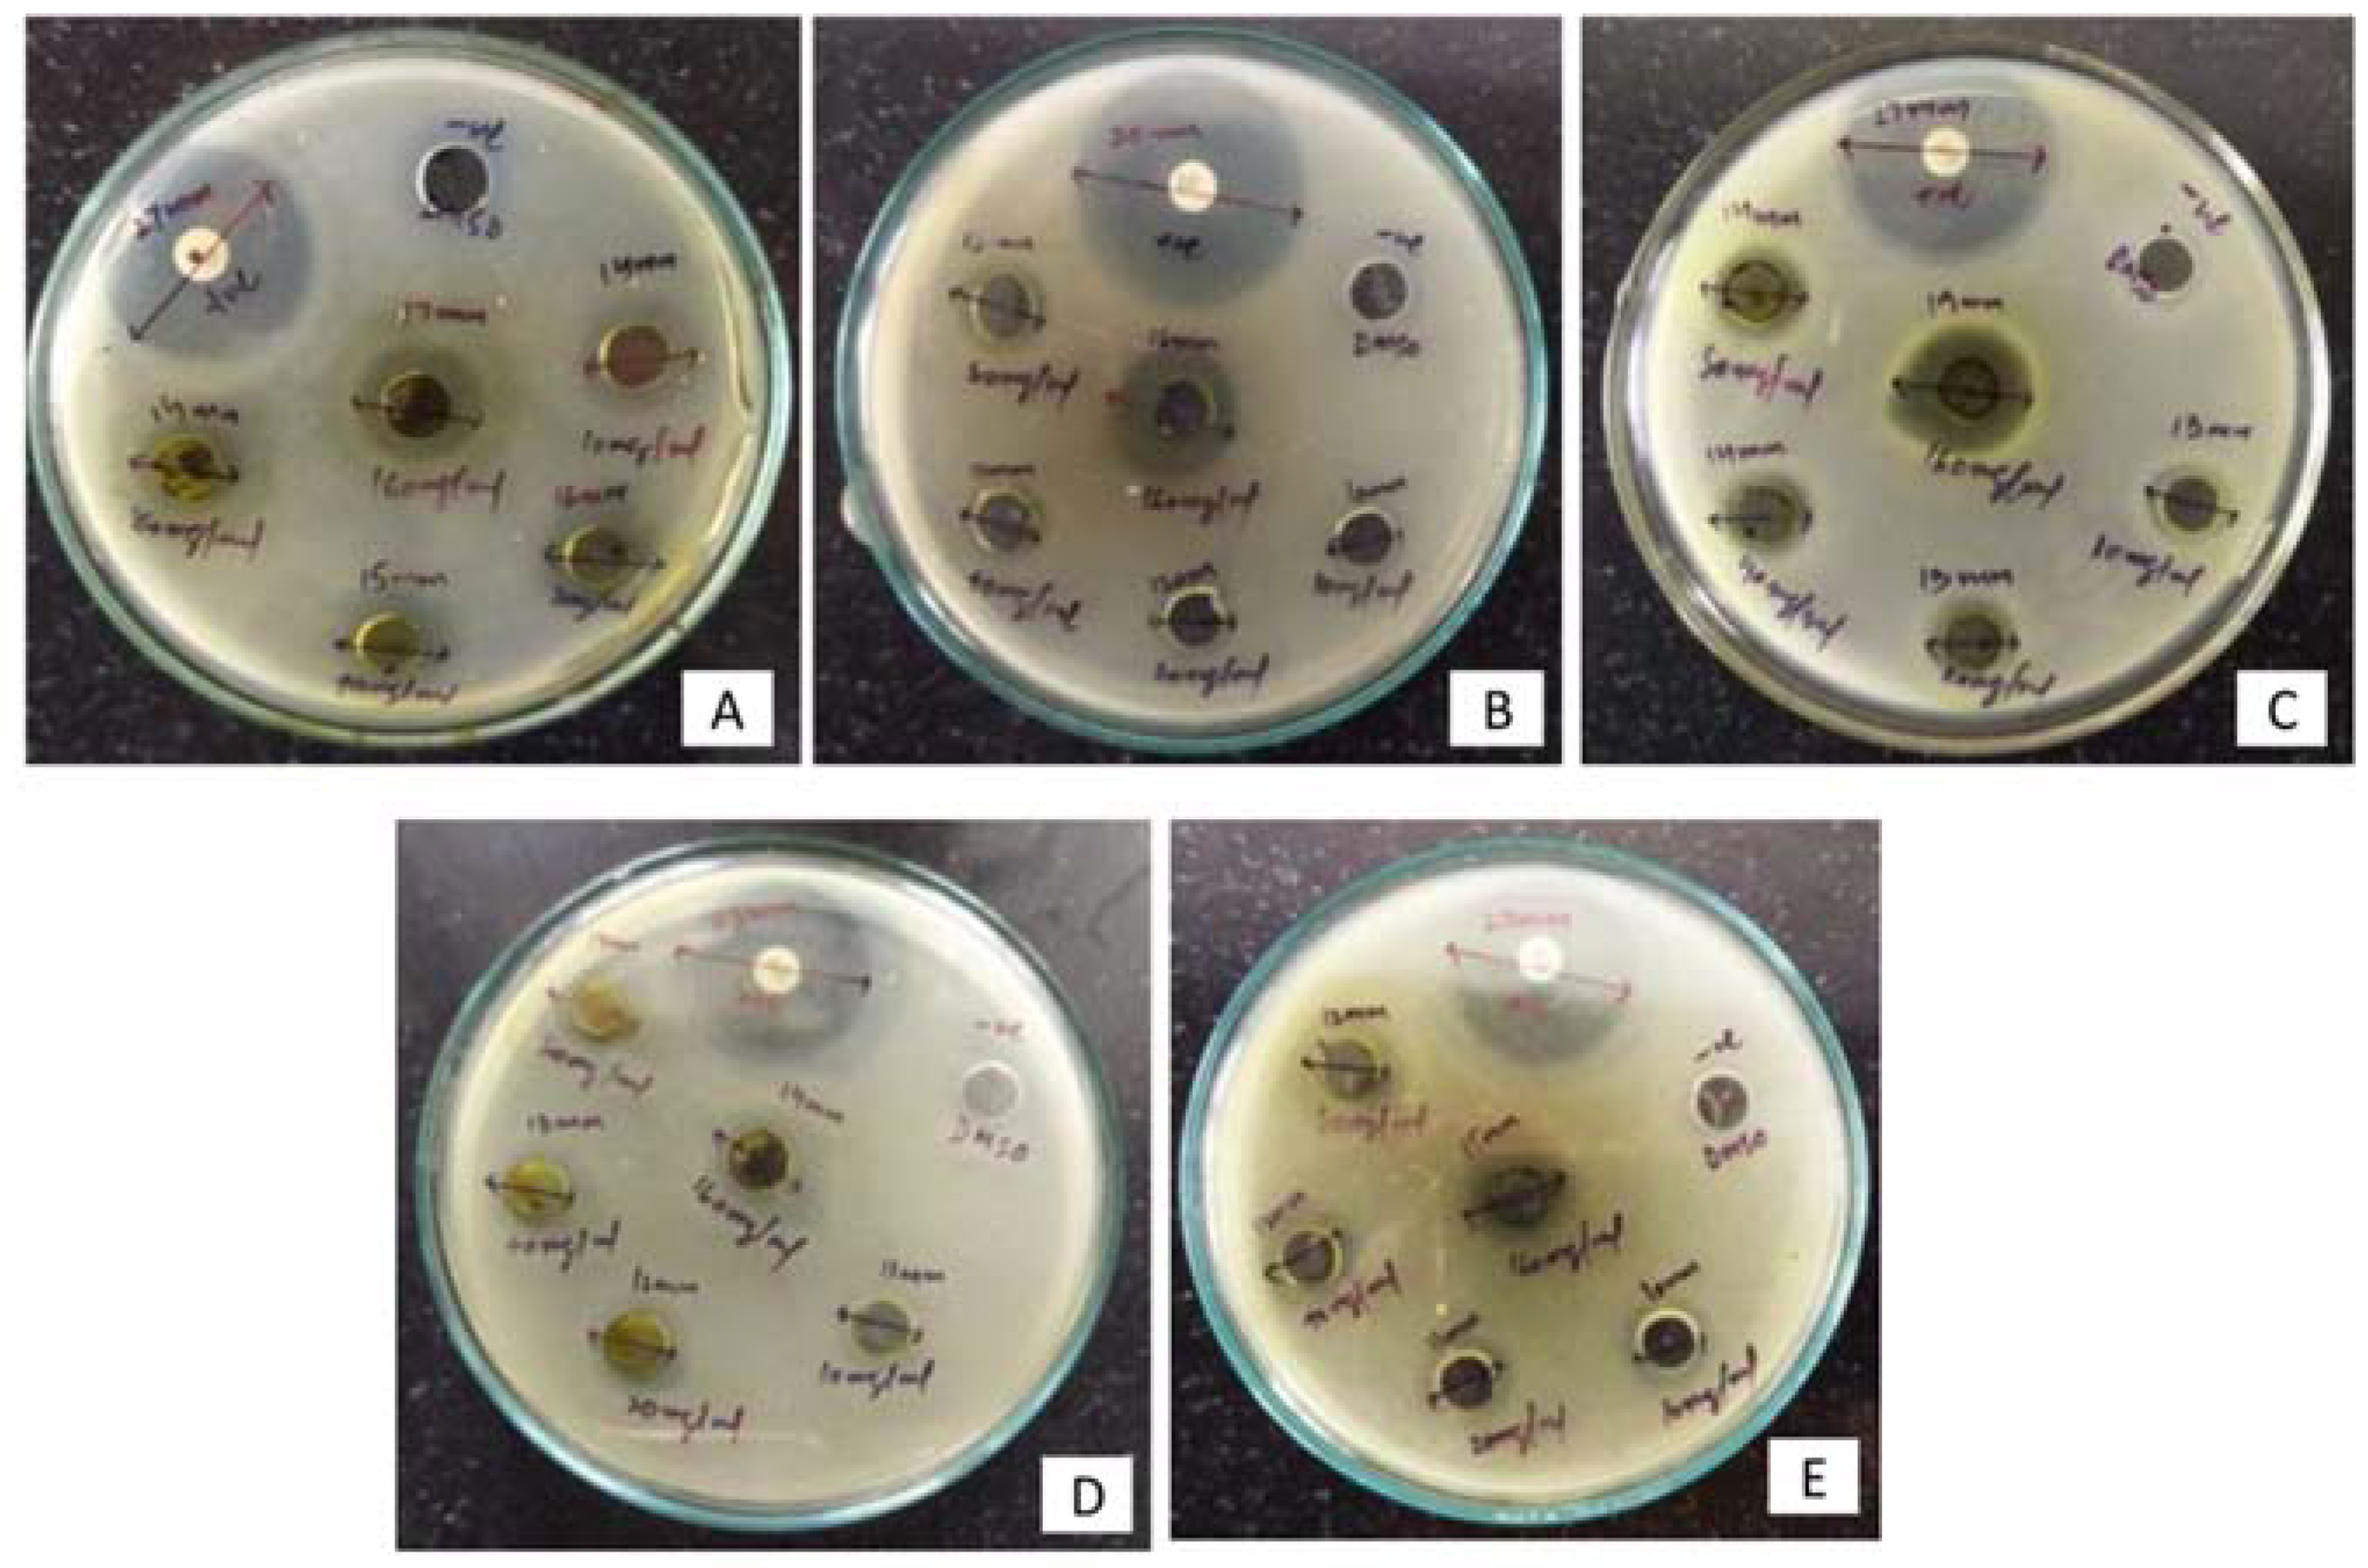
Plants 11 01667 g002

Abstract
Skimmia anquetilia is a plant species native to the Western Himalaya region that has tremendous potential for phytochemical activities. This study aimed to identify bioactive compounds and assess the antibacterial activity of S. anquetilia. To determine the major bioactive chemicals in the methanol leaf extract of S. anquetilia, we used a gas chromatography–mass spectrometer (GC-MS). The presence of 35 distinct phytoconstituents was discovered using GC-MS, which could contribute to the therapeutic capabilities of this plant species. The most predominant compound was 2R-acetoxymethyl-1,3,3-trimethyl-4t-(3-methyl-2-buten-1-yl)-1t-cyclohexanol (23.9%). Further, the leaf extract was evaluated for antibacterial activity against Pseudomonas aeruginosa, Escherichia coli, Klebsiella pneumoniae, Salmonella typhi, and Staphylococcus aureus. The extract showed the highest zone of inhibition against E. coli (19 mm) followed by P. aeruginosa (18 mm) and K. Pneumoniae (17 mm) at 160 mg mL−1. The minimum inhibitory concentration (MIC) of methanol extract against the strain of P. aeruginosa (2 mg mL−1) demonstrated significant antibacterial activity. The findings of the present study highlight the potential of S. anquetilia for the development of herbal medicines for the treatment of various pathogenic infections.
1. Introduction
The increasing interest in medicinal plants instigates from their widespread use in conventional medicines, particularly in developing nations [1]. Contemporary synthetic drugs are often investigated indecisively because they have adverse effects, whereas herbal medicines attract tremendous attention as they are more sustainable, safe, environmentally sound, and free of side effects [2]. Most medicinal plants are unique in their ability to treat and cure various human ailments due to the involvement of numerous useful phytocompounds present in diverse plant components [3]. Various medicinal plants have been employed as traditional remedies in India’s indigenous medicine systems for the treatment of various ailments since ancient times [4]. Currently, about 25% of active principles have been found in medicinal plants that are used as prescription medication items [5]. According to certain studies, indigenous folk and traditional medicine systems have roughly 25,000 plant-specific formulations that are suggested by approximately 1.5 million practitioners for preventative, persuasive, and curative purposes [6].
Important pharmaceutical functions such as anticancerous, antianalgesic, antimicrobial, antiviral, and antioxidant activities are due to the presence of numerous bioactive constituents in medicinal plants [6,7]. Raw plant extracts containing a composite blend of several phytoconstituents are widely used to make plant-based medicines. Such phytoconstituents possess distinctive and composite mechanisms and are intended to treat both long-lasting and infectious diseases [8]. In different plant species, there is a vast reservoir of bioactive compounds, however, only a small section of them have been assessed and continued to be a vital supply of bioactive entities [9]. The implementation of appropriate screening techniques is extremely significant in the quest for novel constituents as well as for quality management [10]. The extraction and structural elucidation of various such bioactive constituents from a variety of medicinal plants has contributed to the supply of some medicinal products with higher potential and quality [11]. Key information on chemical and biological activities is obtained by preliminary analysis of medicinal plants using methods such as spectrometry and chromatography, which enables the identification of bioactive plants [12]. The technique, gas chromatography–mass spectrometry (GC-MS), has been widely used in recent years to identify numerous biologically active compounds found in medicinal plants [9]. Alcohols, alkaloids, nitro-compounds, long-chain hydrocarbons, organic acids, steroids, esters, amino acids, and other bioactive phytoconstituents can all be identified using GC-MS, which requires only a small amount of plant extract [13].
Skimmia anquetilia is a perennial, aromatic, gregarious wild ornamental shrub native to the Western Himalaya [14]. It belongs to the family Rutaceae [15]. The essential oil of the leaves of S. anquetilia possesses linalool, geraniol, β-myrcene, linalyl acetate, umbelliferone, etc., and the plant has been traditionally used to treat headache, smallpox, fever, cold, rheumatism, swelling, and so on [16]. The potentialities of bioactive constituents for their use to treat various diseases must be evaluated. Therefore, the present study is focused on identifying significant functional groups and bioactive constituents from methanolic leaf extract from S. anquetilia via the GC-MS technique and to assess its antibacterial potential.
2. Results
2.1. Phytochemical Screening
Phytochemical screening of S. anquetilia leaf extract revealed the presence of various secondary metabolites, which are listed in Table 1. The phytochemical screening revealed the presence of nearly all of the phytoconstituents studied here, such as alkaloids, cardiac steroidal glycosides, flavonoids, proteins, and amino acids. However, the findings of certain tests were inconsistent. The ninhydrin test showed no proteins and amino acids in the extract, but the xanthoproteic test did. Similarly, the alkaline reagent test and lead acetate tests revealed the existence of flavonoid content in the extract, but the Shinoda test revealed the absence of flavonoid content. Tannins and carbohydrates were not detected in the extract.
Table 1.
Phytochemical screening of methanol leaf extract of Skimmia anquetilia.
2.2. GC-MS Analysis
The representative GC-MS spectra of the methanolic leaf extract of S. anquetilia is presented in Figure 1. The details about different phytochemicals identified by GC-MS with appropriate reverse search matching (RSI) are presented in Table 2. As per National Institute of Standards and Technology (NIST) library guidelines, values between 800–900 are considered a good match, and 900 or above are considered an excellent match. In the present study, the RSI values ranged from more than 800 and 900. The chromatogram of methanol leaf extract of S. anquetilia recorded a total of 35 peaks corresponding to the bioactive compounds that were recognized by relating mass spectral fragmentation patterns to that of the known compounds illustrated by the NIST library. The bioactive compounds in the methanolic leaf extract of S. anquetilia were detected to be: 1,3,5-cycloheptatriene, 2-propenoic acid, butyl ester, geijerene, linalyl acetate, linalool, glycerol 1,2-diacetate, methyl (2E,5E)-2,5-octadecadienoate, geranyl acetate, 3,7,11-trimethyl-3-hydroxy-6,10-dodecadien-1-yl acetate, 3-hydroxypropanoic acid 1-butyl ester, hexadecanoic acid, methyl ester, 2H-1-benzopyran-2-one, 5,7-dimethoxy-, 7H-furo [3,2-g][1]benzopyran-7-one, 4-methoxy-, 5,10-pentadecadienal, (Z,Z)-, photocitral A, 2H-1-benzopyran-2-one, tetradecanoic acid, 7-methoxy-6-(3-methyl-2-butenyl)-, 2R-acetoxymethyl-1,3,3-trimethyl-4t-(3-methyl-2-buten-1-yl)-1t-cyclohexanol, 1,3,3-trimethyl-2-hydroxymethyl-3,3-dimethyl-4-(3-methylbut-2-enyl)-cyclohexene, pentanedioic acid, 2,2-dimethyl-, dimethyl ester, isoauraptene, 10-pentadecen-5-yn-1-ol, (E)-, 2-phenyl-4-ethyl-oxadiazol-1,3,4-one-5, nonacos-1-ene, 2,6,10,14-tetramethylpentadecan-6-ol, 8-(2,3-dihydroxy-3-methylbutyl)-7-methoxy-2H-chromen-2-one, clionasterol acetate, wampetin, (E)-, squalene, (3E,5E,7E)-6-methyl-8-(2,6,6-trimethyl-1-cyclohexenyl)-3,5,7-octatrien-2-one, cyclohexene, 1,5,5-trimethyl-6-(2-propenylidene)-, ergost-5-en-3-ol, (3ß)-, 2-isopropyl-5-methylcyclohexyl 3-(1-(4-chlorophenyl)-3-oxobutyl)-coumarin-4-yl carbonate, and 6ß-hydroxy-17-oxo-4,5-secoandrostan-4-oic acid.
Figure 1.
Representative GC-MS chromatogram for major compounds of methanolic leaf extract of Skimmia anquetilia.
Table 2.
Bioactive compounds of methanolic leaf extract of Skimmia anquetlia identified using GC-MS analysis.
2.3. Antibacterial Activity
The results of antibacterial activity of methanolic leaf extract are presented in Table 3 and Figure 2. The highest zone of inhibition of 19 mm was recorded against E. coli followed by 18 mm and 17 mm against P. aeruginosa and K. pneumoniae, respectively, at 160 mg mL−1 compared with other tested concentrations. The methanol extract showed a minimum inhibitory concentration against P. aeruginosa with a MIC of 2 mg mL−1.
Table 3.
In-vitro antibacterial activity and MIC of S. anquetilia methanol leaf extract against tested bacterial strains.
Figure 2.
The inhibition zones (mm) of methanol leaf extract of Skimmia anquetilia against (A) Escherichia coli (B) Pseudomonas aeruginosa (C) Klebsiella pneumoniae (D) Salmonella typhi, and (E) Staphylococcus aureus.
3. Discussion
In the present investigation, the methanolic leaf extract of S. anquetilia revealed the presence of a wide variety of bioactive compounds, including flavonoids, alcohols, carbohydrates, anthocyanin, cardiac glycosides, tannins, furocoumarins, fatty acids and esters, aldehydes, amino acids, alkanes, alkaloids, steroids, terpenoids, phytosterols, saponins, alkenes, ketones, monoterpenes, and diterpenes etc. These phytocompounds could be responsible for the therapeutic capability of the methanol leaf extract of S. anquetilia. The chemical, 2R-acetoxymethyl-1,3,3-trimethyl-4t-(3-methyl-2-buten-1-yl)-1t-cyclohexanol, isolated from marine Streptomyces sp. VITJS8, has been reported for its antibacterial, antioxidant, and anticancer activities [17]. 1,3,5-Cycloheptatriene has been reported to be present in the chloroform root extract of endophytic fungus Aspergillus terreus var. aureus, exhibiting antitumor activities against HepG2 and Hep-2 cell lines, antioxidant activity, and antimicrobial activity against Escherichia coli, Staphylococcus aureus, and Kelibsiella sp. [18]. The phytoconstituent 1,3,3-trimethyl-2-hydroxymethyl-3,3-dimethyl-4-(3-methylbut-2-enyl)-cyclohexene has been identified in ethanol/methanol wood extract of Populus lasiocarpa [19] and essential oils of Cymbopogon winterianus, Cymbopogon martini, and Pogostemon cablin, exhibiting insecticidal properties [20]. Linalyl acetate is a monoterpene, has been the main constituent of various essential oils known to possess numerous bio-efficacies, for instance anti-inflammatory activity [21], anti-psoriatic activity [22], etc. A furocoumarin compound, wampetin, known to possess anti-inflammatory activity [23] was isolated from the twigs and roots of Clausena lansium [24]. The (3E,5E,7E)-6-methyl-8-(2,6,6-trimethyl-1-cyclohexenyl)-3,5,7-octatrien-2-one has been identified in ethanolic leaf extract of Passiflorain carnata and displayed antitumor activity using an in-silico approach [25]. Similarly, 2-isopropyl-5-methylcyclohexyl 3-(1-(4-chlorophenyl)-3-oxobutyl)-coumarin-4-yl carbonate is a benzopyrone, and 1-hexyl-2-nitro cyclohexane is a ketonic compound and both have been identified from petroleum ether leaf extract of Crateva adansonii and revealed anti-inflammatory properties by using combined analysis viz. in-vitro phytochemical and in-silico studies [26]. Hexadecanoic acid, methyl ester is a fatty acid and has been reported to possess multiple bioactivities such as antioxidant, anticoronary, hepatoprotective, antiacne, anti-inflammatory, antiarthritic, anticancer, antihistaminic, antieczemic, α-reductase inhibitory, and antiandrogenic activities [27]. Likewise, the coumarin compound 7H-furo [3,2-g][1]benzopyran-7-one, 4-methoxy, also known as bergapten, has been isolated from the methanol root extract of Zanthoxylum flavum and exhibited significant antimalarial activity [28]. On the other hand, an aldehydic polar compound, photocitral A, has been extracted from methanol leaf extract of Kalanchoe pinnata and documented with moderate interaction affinity for ion channels, nuclear receptors, and enzyme inhibition activity [29].
From the evidence presented above, it is clear that the S. anquetilia plant contains a variety of pharmacological constituents with important pharmacological properties such as antimicrobial, antioxidant, antitumor, anti-inflammatory, antidiabetic, anticoronary, analgesic, antiaging, anticancer, antipsoriatic, hepatoprotective, hypercholesterolemic, antihistaminic, antiandrogenic, diuretic, and antieczemic, etc. As a result, the discovery of numerous phytochemical components from S. anquetilia’s methanol leaf extract demonstrates the plant’s important therapeutic qualities. Bio-prospecting and other investigations are needed to support the biological qualities and biological value of these new biomolecules.
4. Materials and Methods
4.1. Chemicals and Reagents
All chemicals and reagents used were of analytical grade. Methanol, nutrient agar, Mueller–Hinton agar (MHA) and dimethyl sulfoxide (DMSO) were purchased from E-Merck (Mumbai, India). Gentamycin was procured from Sigma Aldrich (St. Louis, MO, USA).
4.2. Collection and Identification of Plant Material
Skimmia anquetilia N.P. Taylor and Airy Shaw used for the investigation was obtained from the Gulmarg area (74°22′40.01″ N, 34°03′02.26″ E) of the Baramulla District, Kashmir, India at an altitude of 2734 m above msl. The plant specimen was authenticated by Dr. Akhter Hussain Malik, Centre for Biodiversity and Taxonomy (CBT), Kashmir University. The voucher number is 2697-(KASH).
4.3. Sample Extraction
The freshly collected leaf material was thoroughly washed with running tap water and rinsed in distilled water before the leaves were cut into small pieces then dried under shade at room temperature for 15 days, then powdered using a laboratory electric blender. The dried leaf powder (80 g) was extracted using methanol solvent (800 mL) in a soxhlet extractor for 8 h at a temperature below the boiling point of the solvent. Repetitive extraction of the plant material was carried out before the attainment of colourless solvent. The extract was filtered using Whatman No. 1 filter paper, and the acquired filtrate was then evaporated to dryness using a rotary evaporator and stored at 4 °C in an airtight glass container for further analysis [30]. The yield was about 22%.
4.4. Determination of Plant Extract Yield (%)
Yield percentage (%w/w) of the dried extracts was calculated as:
where W1 is the dry weight of extract after solvent evaporation and W2 is the weight of the dried leaf powder.
4.5. Qualitative Phytochemical Analysis
The methanol leaf extracts of S. anquetilia were subjected to qualitative analysis for secondary metabolites including alkaloids, tannins, flavonoids, cardiac steroidal glycosides, proteins and amino acids, and carbohydrates according to the standard methods discussed in the literature [31].
4.6. GC-MS Analysis
Analysis of the leaf extract of Skimmia anquetilia was conducted using the Thermo scientific “Chromeleon” (c) Dionex Version: 7.2.8.10783 (Agilent technologies, Santa Clara, CA, USA) instrument. Helium gas (99.99%) was used as the carrier gas with a flow rate of 1 mL min−1. GC-MS investigation was performed by employing the following conditions: high electron ionization energy (70 eV) was used. Initially furnace temperature was maintained at 60 °C, then raised to 160 °C with a 4 °C min−1 increasing rate and a holding time of approximately 10 min. The temperature was eventually raised at 10 °C min−1 to 350 °C. Then, 1 mL of the sample was kept in a 2 mL screw-top vial in an autoinjector, and 1 μL of the sample was injected in split mode (1:40). The overall run time of the GC was 33 min.
Identification of Compounds
The compounds were identified based on mass spectral patterns with those spectral databases of compounds stored in the NIST electronic library coupled with the GC-MS system. The spectrum of the unknown components was compared with the spectrum of known components stored in the NIST library. The name, molecular weight and molecular formula of the compounds were ascertained.
4.7. Antibacterial Activity
Antibacterial activity of methanol extract of S. anquetilia was determined through the agar well diffusion technique [32]. Tubes with 20 mL of nutrient agar media were inoculated with freshly prepared bacterial inoculums using a sterile loop in a back-and-forth motion to ensure an even distribution of inoculums. Petri plates were prepared by pouring pre-inoculated media and allowing it to solidify and then 8 mm wells were made using a sterile cork borer. A total of 100 μL of different concentrations (10, 20, 40, 80, and 160 mg mL−1) of extract and an equal volume of negative control dimethyl sulfoxide (DMSO) were poured into the wells. The plates were allowed to stand for 30 min to allow pre-diffusion of the extract into the medium and incubated at 37 °C for 17 h. The plates were observed for zones of inhibition after 17 h and results were compared with those of the positive control containing gentamycin (10 μg mL−1).
4.8. Bacterial Strains, Media, and Controls
Five bacterial strains viz., Pseudomonas aeruginosa (MTCC424), Escherichia coli (MTCC739), Klebsiella pneumoniae (MTCC139), Salmonella typhi (MTCC3224), and Staphylococcus aureus (MTCC96) were used in this study; these were procured from the Institute of Microbial Technology (IMTECH), Chandigarh, India. The strains included both Gram-negative as well as Gram-positive strains; for the agar well diffusion assay, all strains were first sub-cultured in nutrient agar media and incubated at 37 °C for 18 ± 2 h. For the antibacterial assay, gentamycin (10 μg mL−1) was used as a positive control, whereas DMSO was used as a negative control.
4.9. Determination of MIC
The agar dilution method [33] was used to determine the antibacterial potential of the methanol extract. A two-fold serial dilution of the extract at varying concentrations from 32 to 0.25 mg mL−1 was prepared in Mueller–Hinton agar (MHA) at 48 °C. Plates were dried at room temperature for 30 min prior to spot inoculation with a loopful of an optimized concentration of each bacterial strain (108 CFU mL−1) using the 0.5 McFarland standard. The negative control included a blank plate containing only MHA. The plates were incubated at 37 °C for 18 h. Experiments were performed in triplicate, the agar plates were observed and compared with the growth in the negative control for their visible bacterial growth both pre- as well as post-incubation. The Minimum inhibitory concentrations (MICs) were determined as the least concentration of extract inhibiting any noticeable growth of each organism on the agar plates.
5. Conclusions
In the present study, Skimmia anquetilia leaves have shown to have various secondary metabolites that possess many pharmacological properties of which antibacterial activity is one. The GC-MS analysis showed the presence of 35 distinct bioactive compounds which contribute to activities such as antifungal, antibacterial, antioxidant, anticancer, antidiabetic, antipsoriatic, anti-inflammatory, and so on. Therefore, the presence of phytochemicals is responsible for the different therapeutic and pharmacological effects. For the development of novel medications based on the bioactive chemicals identified in S. anquetilia, more research is needed to assess its bioactivity, toxicity profile, and clinical investigations.
Author Contributions
Conceptualization, M.N. and B.A.G.; methodology, M.N., M.I.Z. and N.T. and P.A.; software, M.N. and P.A.; validation, S.U.D.W., F.S., S.A. and P.A.; formal analysis, M.N.; investigation, M.N. and N.T.; resources, M.I.Z. and S.A.; data curation, F.S.; writing—original draft preparation, M.N.; writing—review and editing, M.N., F.S., S.A. and B.A.G.; visualization, S.A.; supervision, B.A.G.; project administration, B.A.G.; funding acquisition, S.A. All authors have read and agreed to the published version of the manuscript.
Funding
This research was funded by the Researchers Supporting Project (number RSP-2021/146) at King Saud University, Riyadh, Saudi Arabia and The APC was funded by RSP.
Institutional Review Board Statement
Not applicable.
Informed Consent Statement
Not applicable.
Data Availability Statement
Not applicable.
Acknowledgments
The authors are thankful to the Researchers Supporting Project (number RSP-2021/146) at King Saud University, Riyadh, Saudi Arabia for supporting this research. The first author is grateful to the Centre with Potential of Excellence in Particular Areas (CPEPA), University of Kashmir for providing GC-MS and other laboratory facilities.
Conflicts of Interest
The authors declare no conflict of interest.
References
- Naz, S.; Alam, S.; Ahmed, W.; Khan, S.M.; Qayyum, A.; Sabir, M.; Naz, A.; Iqbal, A.; Bibi, Y.; Nisa, S.; et al. Therapeutic potential of selected medicinal plant extracts against multi-drug resistant Salmonella enterica serovar typhi. Saudi J. Biol. Sci. 2022, 29, 941–954. [Google Scholar] [CrossRef] [PubMed]
- Karimi, A.; Majlesi, M.; Rafieian-Kopaei, M. Herbal versus synthetic drugs; beliefs and facts. J. Nephropharmacol. 2015, 4, 27–30. [Google Scholar] [PubMed]
- Prasathkumar, M.; Anisha, S.; Dhrisya, C.; Becky, R.; Sadhasivam, S. Therapeutic and pharmacological efficacy of selective Indian medicinal plants—A review. Phytomed. Plus 2021, 1, E100029. [Google Scholar] [CrossRef]
- Konappa, N.; Udayashankar, A.C.; Krishnamurthy, S.; Pradeep, C.K.; Chowdappa, S.; Jogaiah, S. GC-MS analysis of phytoconstituents from Amomum nilgiricum and molecular docking interactions of bioactive serverogenin acetate with target proteins. Sci. Rep. 2020, 10, E16438. [Google Scholar] [CrossRef] [PubMed]
- Süntar, I. Importance of ethnopharmacological studies in drug discovery: Role of medicinal plants. Phytochem. Rev. 2020, 19, 1199–1209. [Google Scholar] [CrossRef]
- Pandey, M.M.; Rastogi, S.; Rawat, A.K.S. Indian traditional ayurvedic system of medicine and nutritional supplementation. Evid. Based Complement. Altern. Med. 2013, 2013, E376327. [Google Scholar] [CrossRef] [Green Version]
- Parham, S.; Kharazi, A.Z.; Bakhsheshi-Rad, H.R.; Nur, H.; Ismail, A.F.; Sharif, S.; Berto, F. Antioxidant, antimicrobial and antiviral properties of herbal materials. Antioxidants 2020, 9, 1309. [Google Scholar] [CrossRef]
- Sofi, H.S.; Rashid, R.; Amna, T.; Hamid, R.; Sheikh, F.A. Recent advances in formulating electrospunnaofiber membranes: Delivering active phytoconstituents. J. Drug Deliv. Sci. Technol. 2020, 60, E102038. [Google Scholar] [CrossRef]
- Koparde, A.A.; Doijad, R.C.; Magdum, C.S. Natural products in drug discovery. In Pharmacognosy: Medicinal Plants; IntechOpen: Rijeka, Croatia, 2019; Available online: https://www.intechopen.com/books/pharmacognosy-medicinal-plants/natural-products-in-drug-discovery (accessed on 13 July 2021).
- Pan, S.Y.; Zhou, S.F.; Gao, S.H.; Yu, Z.L.; Zhang, S.F.; Tang, M.K.; Sun, J.N.; Ma, D.L.; Han, Y.F.; Fong, W.F.; et al. New perspectives on how to discover drugs from herbal medicines: CAM’s outstanding contribution to modern therapeutics. Evid. Based Complement. Altern. Med. 2013, 2013, E627375. [Google Scholar] [CrossRef] [Green Version]
- Altemimi, A.; Lakhssassi, N.; Baharlouei, A.; Watson, D.G.; Lightfoot, D.A. Phytochemicals: Extraction, isolation, and identification of bioactive compounds from plant extracts. Plants 2017, 6, 42. [Google Scholar] [CrossRef]
- Belščak-Cvitanović, A.; Valinger, D.; Benković, M.; Tušek, A.J.; Jurina, T.; Komes, D.; GajdošKljusurić, J. Integrated approach for bioactive quality evaluation of medicinal plant extracts using HPLC-DAD, spectrophotometric, near infrared spectroscopy and chemometric techniques. Int. J. Food Prop. 2017, 20, S2463–S2480. [Google Scholar] [CrossRef]
- Nivetha, K.; Prasanna, G. GC-MS and FT-IR analysis of Nigella sativa L. seeds. Int. J. Adv. Res. Biol. Sci. 2016, 3, 45–54. [Google Scholar]
- Sourabh, P.; Thakur, J.; Sharma, P.; Uniyal, P.L.; Pandey, A.K. Habitat distribution modelling for reintroduction of endangered medicinal plants-Ephedra gerardiana, Lilium polyphyllum, Crepidiumacuminatum, Pittosporum eriocarpum and Skimmia anquetilia in India. Int. J. Ecol. Environ. Sci. 2018, 44, 207–216. [Google Scholar]
- WFO. Skimmia anquetilia N.P. Taylor & Airy. World Flora Online. Available online: http://www.worldfloraonline.org/taxon/wfo-0000504241 (accessed on 13 July 2021).
- Gondwal, M.; Prakash, O.; Vivekanand; Pant, A.K.; Padalia, R.C.; Mathela, C.S. Essential oil composition and antioxidant activity of leaves and flowers of Skimmia anquetilia NP Taylor & Airy Shaw. J. Essent. Oil Res. 2012, 24, 83–90. [Google Scholar]
- Naine, S.J.; Devi, C.S.; Mohanasrinivasan, V.; Doss, C.G.P.; Kumar, D.T. Binding and molecular dynamic studies of sesquiterpenes (2R-acetoxymethyl-1,3,3-trimethyl-4t-(3-methyl-2-buten-1-yl)-1t-cyclohexanol) derived from marine Streptomyces sp. VITJS8 as potential anticancer agent. Appl. Microbiol. Biotechnol. 2016, 100, 2869–2882. [Google Scholar] [CrossRef]
- Abo-Dahab, N.F. Analysis of bioactive compounds of Aspergillus terreus var. Aureus isolated from Artemisia annua L. Afr. J. Mycol. Biotechnol. 2014, 19, 17–29. [Google Scholar]
- Peng, W.; Li, D.; Zhang, M.; Ge, S.; Mo, B.; Li, S.; Ohkoshi, M. Characteristics of antibacterial molecular activities in poplar wood extractives. Saudi J. Biol. Sci. 2017, 24, 399–404. [Google Scholar] [CrossRef] [Green Version]
- Devi, M.A.; Nameirakpam, B.; Devi, T.B.; Mayanglambam, S.; Singh, K.D.; Sougrakpam, S.; Rajashekar, Y. Chemical compositions and insecticidal efficacies of four aromatic essential oils on rice weevil Sitophilus oryzae L. Int. J. Trop. Insect Sci. 2020, 40, 549–559. [Google Scholar] [CrossRef]
- Peana, A.T.; D’Aquila, P.S.; Panin, F.; Serra, G.; Pippia, P.; Moretti, M.D.L. Anti-inflammatory activity of linalool and linalyl acetate constituents of essential oils. Phytomedicine 2002, 9, 721–726. [Google Scholar] [CrossRef]
- Rai, V.K.; Sinha, P.; Yadav, K.S.; Shukla, A.; Saxena, A.; Bawankule, D.U.; Yadav, N.P. Anti-psoriatic effect of Lavandula angustifolia essential oil and its major components linalool and linalyl acetate. J. Ethnopharmacol. 2020, 261, E113127. [Google Scholar] [CrossRef]
- Shen, D.Y.; Kuo, P.C.; Huang, S.C.; Hwang, T.L.; Chan, Y.Y.; Shieh, P.C.; Wu, T.S. Constituents from the leaves of Clausenalansium and their anti-inflammatory activity. J. Nat. Med. 2017, 71, 96–104. [Google Scholar] [CrossRef] [PubMed]
- Rodanant, P.; Surarit, R.; Laphookhieo, S.; Kuvatanasuchati, J. In vitro evaluation of the antibacterial and anti-inflammation activities of Clausenalansium (Lour.) Skeels. Songklanakarin J. Sci. Technol. 2015, 37, 43–48. [Google Scholar]
- Sujana, N.; Ramanathan, S.A.; Vimala, V.E.; Sundaram, M.E.; Pemaiah, B. Antitumour potential of Passifloraincarnata against ehrlich ascites carcinoma. Int. J. Pharm. Pharm. Sci. 2012, 4, 10–13. [Google Scholar]
- Thirumalaisamy, R.; Ammashi, S.; Muthusamy, G. Screening of anti-inflammatory phytocompounds from Cratevaadansonii leaf extracts and its validation by in silico modeling. J. Genet. Eng. Biotechnol. 2018, 16, 711–719. [Google Scholar] [CrossRef]
- Krishnamoorthy, K.; Subramaniam, P. Phytochemical profiling of leaf, stem, and tuber parts of Solenaamplexicaulis (Lam.) Gandhi using GC-MS. Int. Sch. Res. Not. 2014, 2014, E567409. [Google Scholar]
- Ross, S.A.; Krishnaven, K.; Radwan, M.M.; Takamatsu, S.; Burandt, C.L. Constituents of Zanthoxylum flavum and their antioxidant and antimalarial activities. Nat. Prod. Commun. 2008, 3, 791–794. [Google Scholar] [CrossRef] [Green Version]
- Agarwal, H.; Shanmugam, V.K. Anti-inflammatory activity screening of Kalanchoe pinnata methanol extract and its validation using a computational simulation approach. Inform. Med. Unlocked 2019, 14, 6–14. [Google Scholar] [CrossRef]
- Foudah, A.I.; Shakeel, F.; Alqarni, M.H.; Ali, A.; Alshehri, S.; Ghoneim, M.M.; Alam, P. Determination of thymol in commercial formulation, essential oils, traditional, and ultrasound-based extracts of Thymus vulagris and Origanum vulgare using a greener HPTLC approach. Molecules 2022, 27, 1164. [Google Scholar] [CrossRef]
- Gul, R.; Jan, S.U.; Faridullah, S.; Sherani, S.; Jahan, N. Preliminary phytochemical screening, quantitative analysis of alkaloids, and antioxidant activity of crude plant extracts from Ephedra intermedia indigenous to Balochistan. Sci. World J. 2017, 2017, E5873648. [Google Scholar] [CrossRef] [Green Version]
- Valgas, C.; Souza, S.M.D.; Smânia, E.F.; Smânia, A., Jr. Screening methods to determine antibacterial activity of natural products. Braz. J. Microbiol. 2007, 38, 369–380. [Google Scholar] [CrossRef] [Green Version]
- Bousmaha-Marroki, L.; Boutillier, D.; Marroki, A.; Grangette, C. In vitro anti-staphylococcal and anti-inflammatory abilities of Lacticaseibacillus rhamnosus from infant gut microbiota as potential probiotic against infectious women mastitis. Probiotics Antimirob. Proteins 2021, 13, 970–981. [Google Scholar] [CrossRef] [PubMed]
Publisher’s Note: MDPI stays neutral with regard to jurisdictional claims in published maps and institutional affiliations. |
© 2022 by the authors. Licensee MDPI, Basel, Switzerland. This article is an open access article distributed under the terms and conditions of the Creative Commons Attribution (CC BY) license (https://creativecommons.org/licenses/by/4.0/).